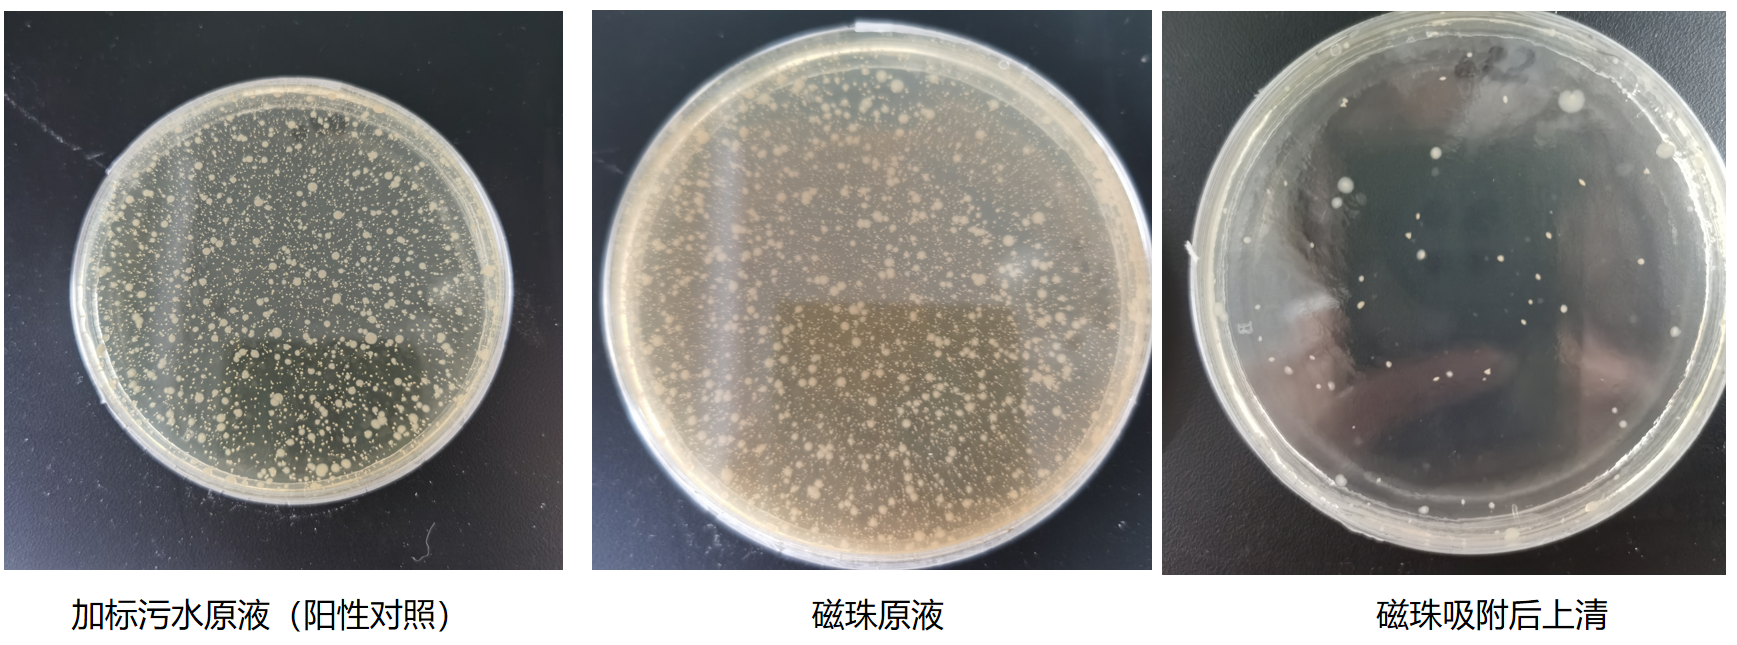
3.png

让污水监测更简便:提升污水检测精度,简化操作流程,极速完成大规模检测
污水流行病学作为一门新兴的公共卫生监测技术,近年来在全球范围内逐渐受到关注,尤其是在应对传染病暴发和评估公共健康状况方面显示出巨大的潜力。目前,我国主要采用聚乙二醇沉淀法、铝盐混凝沉淀法和离心超滤法来浓缩污水中的新冠病毒。这三种方法凭借稳定性好以及规范化的操作流程而广泛应用。与此同时,磁珠法因其高效和自动化等优势,正逐渐被各科研机构和疾控单位所采纳。
污水分子浓缩仪是我团队推出的一款全自动浓缩、富集和纯化系统,利用磁珠法原理,用于从污水样本中浓缩病原微生物、核酸、蛋白质及化学小分子化合物。目前,该仪器已成功应用于生活污水及其他水体样本中新冠(SARS-CoV-2)、猴痘、流感、肠道和登革热病毒的自动化浓缩与富集。该产品旨在提高污水病原体检测的灵敏度和准确性,简化操作流程,提升样品处理的速度与效率,从而减少人力投入。
产品参数
| 产品型号 | WMC-24C |
样品通量 | 1-24 |
处理体积 | 50-5000 μL/50-10000 μL |
提纯灵敏度 | 10 拷贝样品的阳性检出率> 95% |
样本处理 | 在同一仪器内部全自动完成样本的浓缩富集及核酸提取,无需手动干预,浓缩后的样本可直接用于定量PCR、数字PCR和测序等分子检测方法,无需另外提取 |
产品优势
同时可检测24份样本,单次上机时间45 min,一键启动,操作简单。
支持单样本上机且无需额外核酸提取步骤,无需担心试剂浪费。
多数病原体方法检出限5 copies/mL,单份污水样本仅需8 mL即可完成浓缩过程。
应用场景广泛,配备不同试剂盒可完成细菌、病毒培养式浓缩和化学物质浓缩过程。
应用场景
多病原监测:用于污水中多种病原体监测, 如新冠病毒、猴痘病毒、流感病毒、诺如病毒、腺病毒、沙门氏菌、霍乱弧菌等检测。
微生物培养:环境水体中细菌等微生物的自动化浓缩富集,富集于磁珠或截留在滤膜上微生物可用于进一步培养纯化。
化学小分子监测:可用于污水样本中抗生素、全氟化合物、违禁农兽药等化学物质的监测。
应用实例
实例1 污水监测猴痘(非培养模式)

污水分子浓缩仪成功参与了我国首例污水监测猴痘病例的研究。实验比较结果显示,与超滤设备相比,污水分子浓缩仪猴痘病毒的方法回收率为34.3%-94.7%,检出限为5 copies/mL,具有显著优势,并且与改良聚乙二醇法检测能力相匹配。(搭配污水病毒浓缩富集试剂盒(磁珠法)(WMXJC024-1/2))
[Xu, Jin, et al. "The first detection of mpox virus DNA from wastewater in China." Science of The Total Environment (2024): 172742.]

实例2 污水监测致病菌 (培养模式)
配合污水分子浓缩仪以及污水病原菌专用富集试剂盒对污水中病原菌进行浓缩富集,富集后的磁珠吸附的病原菌可以成功培养,富集后污水中病原菌数量显著减少,磁珠捕获效率可达91%。(搭配污水细菌浓缩富集试剂盒(磁珠法)(WMXJE025-1))
实例3 污水处理厂污水小分子药物检出情况

配合污水分子浓缩仪以及新开发的化学小分子专用富集试剂盒对特定区域内主要污水处理厂进水样本进行分析检测,成功检出目标药物成分主要包括地西泮、金刚烷胺、氧氟沙星以及诺氟沙星等,检出限≤1ng/L。此方案可拓展应用于多种水体样本中各类化学小分子化合物(配合专用的试剂盒产品)的检测分析工作。(搭配污水化学小分子富集试剂盒(磁珠法)(WMXJE025-1))